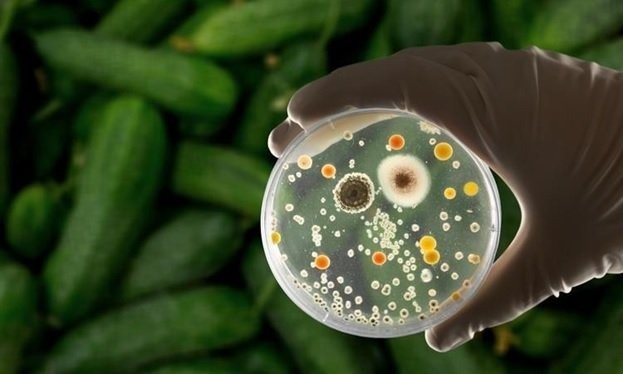

When people hear that food can “kill,” they often imagine poison, chemicals, or something obviously rotten. But the reality is quieter and more unsettling. Some of the most ordinary foods in our kitchens can become deadly—not because of what they are, but because of the bacteria growing inside them.
Bacteria are invisible. They don’t change the taste right away. They don’t always create a foul smell. And sometimes the food looks perfectly normal. Yet under the right conditions—poor storage, cross-contamination, improper cooking—common ingredients can turn into vehicles for life-threatening infections.
This article explores foods that can become deadly through bacterial contamination, the specific organisms involved, and why they are so dangerous.
Raw and Undercooked Poultry
Few foods are as strongly associated with bacterial illness as chicken and turkey. Raw poultry frequently carries bacteria such as Salmonella and Campylobacter. These microorganisms live naturally in the intestines of birds and can easily contaminate meat during slaughter and processing.
Salmonella infections can cause severe diarrhea, dehydration, high fever, and in vulnerable individuals—infants, elderly people, or those with weakened immune systems—can spread into the bloodstream. When that happens, the infection becomes life-threatening.
Campylobacter is less famous but just as dangerous. It can trigger intense abdominal pain, bloody diarrhea, and in rare cases, long-term complications like Guillain-Barré syndrome, a neurological condition that can cause paralysis.
The danger with poultry is simple: it must be cooked thoroughly. Even slightly undercooked chicken can harbor live bacteria. What makes this particularly risky is cross-contamination. A knife used on raw chicken and then used on salad vegetables without washing can silently transfer bacteria to food that won’t be cooked at all.
The chicken itself may not look suspicious. That’s part of the problem.
Raw Eggs
Eggs seem harmless. They’re sealed in shells, clean, and neatly packaged. But Salmonella can sometimes be present inside the egg itself, not just on the shell surface.
Dishes made with raw or lightly cooked eggs—such as homemade mayonnaise, mousse, tiramisu, or certain sauces—can become vehicles for infection. The risk increases when eggs are stored improperly or used past their safe date.
In most healthy adults, Salmonella causes severe gastrointestinal distress. However, in children and older adults, dehydration can happen quickly. In severe cases, bacteria can enter the bloodstream, leading to sepsis.
Pasteurized eggs dramatically reduce this risk, but many home cooks don’t think about bacterial contamination when cracking an egg into a recipe. It feels natural. Safe. Routine. Yet under certain conditions, it can turn dangerous.
Ground Beef
Whole cuts of beef usually carry bacteria on the surface. When properly seared, high heat kills surface microbes. But ground beef is different.
Grinding mixes surface bacteria throughout the meat. That means harmful organisms like E. coli O157:H7 can end up inside the burger, where surface heat may not reach if it’s cooked rare.
Certain strains of E. coli produce Shiga toxins. These toxins damage blood vessels and can lead to a condition called hemolytic uremic syndrome (HUS), which can cause kidney failure—especially in children.
Undercooked hamburgers have been responsible for deadly outbreaks in the past. The frightening part is that contaminated meat doesn’t always look spoiled. The color can be normal. The smell unchanged.
Only proper cooking to a safe internal temperature eliminates the risk.
Unpasteurized Milk and Soft Cheeses
Raw milk has gained popularity in some circles due to claims of health benefits. However, unpasteurized dairy can harbor dangerous bacteria including Listeria monocytogenes, Salmonella, and E. coli.
Listeria is particularly concerning because it can grow at refrigerator temperatures. Unlike many bacteria that slow down in the cold, Listeria continues multiplying. This makes soft cheeses made from raw milk especially risky.
In pregnant women, Listeria infection can lead to miscarriage, stillbirth, or severe neonatal infection. In older adults, it can cause meningitis and sepsis.
Pasteurization exists for a reason. It’s not just industrial overprocessing—it’s a safety measure developed after countless deadly outbreaks in the past.
Leafy Greens and Raw Vegetables
Salads feel healthy. Clean. Safe. Yet leafy greens like spinach, lettuce, and arugula have been linked to serious E. coli outbreaks.
The problem often begins before the vegetables reach the supermarket. Contaminated irrigation water, contact with animal waste, or improper handling during processing can introduce bacteria. Because these vegetables are eaten raw, there is no cooking step to kill pathogens.
When contamination occurs, outbreaks can spread widely across regions because packaged greens are distributed nationally. One batch can affect thousands of people.
Symptoms of severe E. coli infection can escalate quickly. Bloody diarrhea, intense cramps, and in rare cases kidney failure. It’s an unsettling reminder that even something as simple as a salad can become dangerous under the wrong conditions.
Deli Meats and Ready-to-Eat Processed Foods
Deli meats are convenient. No cooking required. Just slice and eat. But that convenience is exactly what makes them risky.
Listeria contamination has been repeatedly linked to sliced meats, hot dogs, and ready-to-eat refrigerated foods. Since these products are not reheated before consumption, bacteria survive.
Listeria’s ability to grow in cold environments makes it particularly problematic in processing facilities. Once it establishes itself in equipment, it can be difficult to eliminate.
For healthy adults, symptoms may resemble flu-like illness. For vulnerable populations, it can be fatal.
Reheating deli meats until steaming hot significantly reduces the risk—but many people skip that step entirely.
Seafood and Raw Shellfish
Raw oysters and shellfish carry a certain luxury image, but they also pose serious bacterial risks.
Vibrio vulnificus is a marine bacterium found in warm coastal waters. When consumed in raw oysters, it can cause severe bloodstream infections, especially in individuals with liver disease or weakened immune systems. Mortality rates are high once septicemia develops.
Unlike some foodborne illnesses that cause only gastrointestinal symptoms, Vibrio infections can rapidly become systemic and life-threatening.
Cooking destroys Vibrio. Eating raw shellfish does not.
Cooked Rice Left at Room Temperature
This one surprises people.
Rice itself is not inherently dangerous. But uncooked rice can contain spores of Bacillus cereus. These spores survive cooking. If cooked rice is left at room temperature for hours, spores can germinate and produce toxins.
Reheating may kill the bacteria—but it does not destroy the toxins already formed.
The result can be severe vomiting or diarrhea. In rare cases, particularly with vulnerable individuals, complications can escalate.
It’s a reminder that food safety is not only about what you eat, but how long it sits out before you eat it.
How Bacterial Toxins Turn Ordinary Food Into Deadly Threats
Sprouts: Tiny Plants, Big Risk
Sprouts look fresh and harmless. Alfalfa, mung bean, radish, broccoli—these small shoots are often marketed as health foods, packed with enzymes and nutrients. But the very conditions that allow sprouts to grow also allow bacteria to multiply rapidly.
Sprouts require warmth, moisture, and time. Unfortunately, those are also perfect conditions for bacteria like Salmonella and E. coli to thrive. Contamination often occurs at the seed level, before sprouting even begins. Once bacteria are present, the sprouting process amplifies them.
Because sprouts are typically eaten raw, there is no cooking step to eliminate pathogens. Several major outbreaks across the world have been traced back to contaminated sprouts, with cases of kidney failure and even death reported.
For pregnant women, elderly individuals, and those with weakened immune systems, raw sprouts are often considered too risky to consume.
Improperly Canned Foods
Home canning has a long tradition. It feels wholesome and self-sufficient. But if done incorrectly, it can create one of the deadliest foodborne threats: Clostridium botulinum.
This bacterium produces botulinum toxin, one of the most powerful toxins known. In sealed, oxygen-free environments like improperly canned vegetables, meats, or fish, the bacteria can grow and release toxin without obvious signs of spoilage.
Botulism affects the nervous system. It blocks nerve signals to muscles, causing progressive paralysis. Early symptoms may include blurred vision, difficulty swallowing, and weakness. Without rapid treatment, respiratory failure can occur.
What makes botulism especially dangerous is that even a tiny amount of toxin can be lethal. Food may look normal. Smell normal. Taste normal. But the toxin can already be present.
Commercial canning processes use strict temperature and pressure controls for this reason. At home, precision matters.
Refrigerated Pasta and Potato Salads
Cooked starches—pasta, potatoes, grains—can also become hazardous when stored improperly. Like rice, they may harbor Bacillus cereus spores. If left at room temperature too long before refrigeration, bacteria multiply and produce toxins.
Large gatherings and buffets are common scenarios. A tray of potato salad sits out for hours. People eat small portions over time. By the time symptoms appear—vomiting, diarrhea, abdominal cramps—the contamination has already occurred.
Food poisoning from Bacillus cereus is often dismissed as mild, but in extreme cases dehydration can become severe, especially in children and elderly individuals.
The rule is simple but often ignored: hot foods should stay hot, and cold foods should stay cold. The danger zone—roughly between 4°C and 60°C—is where bacteria grow most rapidly.
Fresh Fruit Contamination
Fruit seems inherently safe. Its natural acidity protects against many pathogens. But contamination can still occur, particularly through handling and processing.
Pre-cut fruits, melon slices, and packaged fruit salads are especially vulnerable. Once the protective skin is removed, the moist flesh becomes a breeding ground for bacteria if stored improperly.
Listeria has been linked to cantaloupes. Salmonella has been found on mangoes and papayas. In some outbreaks, entire shipments had to be recalled after illnesses and deaths were reported.
The risk increases when fruits are cut in large batches and distributed widely. A single contaminated processing line can affect thousands of consumers.
Washing whole fruits helps reduce surface contamination. Refrigeration slows bacterial growth. But once fruit is cut, time becomes critical.
The Role of Bacterial Toxins
Not all foodborne illness works the same way. Sometimes bacteria invade the body and multiply inside the intestines or bloodstream. Other times, the bacteria produce toxins in the food before it is eaten.
These toxins are often more dangerous than the bacteria themselves.
Shiga toxins from certain E. coli strains damage blood vessels and kidneys. Botulinum toxin blocks nerve transmission, leading to paralysis. Staphylococcus aureus produces toxins that cause rapid vomiting, sometimes within hours.
In toxin-mediated illness, reheating the food may kill the bacteria but not destroy the toxin. That’s why simply “warming leftovers” isn’t always a guaranteed fix.
The human body responds violently to these toxins. Severe dehydration, electrolyte imbalance, organ failure, and septic shock can follow in extreme cases.
Why Some People Die and Others Recover
One unsettling reality of foodborne bacteria is that not everyone responds the same way.
A healthy adult may experience several miserable days of diarrhea and recover fully. A young child exposed to the same pathogen might develop kidney failure. An elderly person might develop sepsis.
Immune strength, stomach acidity, underlying health conditions, and even genetics influence outcomes.
People with liver disease are particularly vulnerable to Vibrio infections from raw seafood. Pregnant women are uniquely susceptible to Listeria complications. Individuals undergoing chemotherapy face higher risks from nearly all foodborne pathogens.
Food that is “usually safe” can become deadly under the wrong circumstances.
How Bacteria Actually Kill
Death from foodborne illness typically doesn’t happen directly from diarrhea alone. The process is more complex.
Severe dehydration can lead to low blood pressure and organ damage. Invasive bacteria can enter the bloodstream, causing sepsis—a life-threatening inflammatory response that can lead to multi-organ failure.
Certain toxins, like botulinum toxin, directly shut down vital bodily functions such as breathing.
Kidney failure from hemolytic uremic syndrome can occur after specific E. coli infections. This condition is especially dangerous in children and may require dialysis.
While modern medicine has significantly reduced mortality from foodborne illness, outbreaks still claim lives each year. Often the victims are the most vulnerable.
Reducing the Risk Without Living in Fear
The purpose of understanding these dangers is not to create paranoia. It’s to promote awareness.
Most bacterial foodborne illness is preventable through simple practices:
Cook meats thoroughly.
Avoid cross-contamination between raw and cooked foods.
Refrigerate leftovers promptly.
Reheat foods properly.
Be cautious with raw dairy and raw seafood.
Wash hands and surfaces regularly.
These habits may seem basic, but they interrupt the chain of bacterial growth and toxin production.
Food has sustained humanity for thousands of years. It remains one of life’s great pleasures. But beneath its comfort and familiarity lies biology—microscopic life that follows its own rules.
When those rules are ignored, ordinary meals can become dangerous. When respected, the risks drop dramatically.
Understanding how bacteria turn food deadly is less about fear—and more about control.